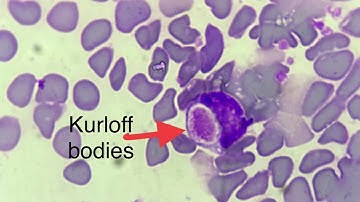
Foa-kurloff cells in Guinea pig blood smear

⬇ DOWNLOAD NOW
Kalau muncul iklan pop-up, tutup lalu klik tombol kembali
Download lagu how to take guinea pig blood to make complementary for brucella CFT testing secara gratis hanya untuk keperluan promosi. Dukung artis favorit kamu dengan membeli musik original di iTunes atau platform resmi lainnya.
 Guinea Pig Blood Sample
Guinea Pig Blood Sample
 Guinea pig blood sample
Guinea pig blood sample
 IDEXX - How to make a Blood Film in 3 steps
IDEXX - How to make a Blood Film in 3 steps
 Brucella A+M Video
Brucella A+M Video
 How to collect blood for brucellosis test kit
How to collect blood for brucellosis test kit
Foa-kurloff cells in Guinea pig blood smear
Foa-kurloff cells in Guinea pig blood smear
 How to Create a Great Veterinary Blood Smear
How to Create a Great Veterinary Blood Smear
 Collection of blood sample from guinea pigs with capillary
Collection of blood sample from guinea pigs with capillary